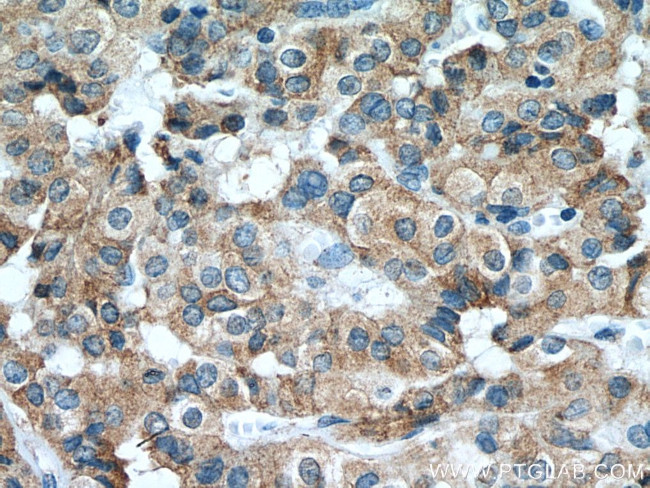
calreticulin Antibody in Immunohistochemistry (Paraffin) (IHC (P))

Search
Proteintech
calreticulin Recombinant Rabbit Monoclonal Antibody (2B17)
{{$productOrderCtrl.translations['antibody.pdp.commerceCard.promotion.promotions']}}
{{$productOrderCtrl.translations['antibody.pdp.commerceCard.promotion.viewpromo']}}
{{$productOrderCtrl.translations['antibody.pdp.commerceCard.promotion.promocode']}}: {{promo.promoCode}} {{promo.promoTitle}} {{promo.promoDescription}}. {{$productOrderCtrl.translations['antibody.pdp.commerceCard.promotion.learnmore']}}
图: 1 / 5
calreticulin Antibody (80017-1-RR100UL) in IHC (P)





产品信息
80017-1-RR100UL
种属反应
宿主/亚型
Expression System
分类
类型
克隆号
偶联物
形式
浓度
规格
纯化类型
保存液
内含物
保存条件
运输条件
靶标信息
Calr or Calreticulin is a calcium-binding chaperone that promotes folding, oligomeric assembly and quality control in the endoplasmic reticulum (ER) via the calreticulin/calnexin cycle. Calr, a lectin, interacts transiently with almost all of the monoglucosylated glycoproteins that are synthesized in the ER. Calr also interacts with with the DNA-binding domain of NR3C1 and mediates its nuclear export. It may also be involved in maternal gene expression regulation and oocyte maturation via the regulation of calcium homeostasis.
仅用于科研。不用于诊断过程。未经明确授权不得转售。
篇参考文献 (0)
生物信息学
蛋白别名: Autoantigen RO; CABP3; CALBP; Calcium-binding protein 3; CALR; Calregulin; Calreticulin; CRP55; Endoplasmic reticulum resident protein 60; epididymis secretory sperm binding protein Li 99n; ERp60; FLJ26680; grp60; HACBP; Ro ribonucleoprotein autoantigen (Ro/SS-A) precursor; Ro/SS-A Antigen; Sicca syndrome antigen A (autoantigen Ro; calreticulin); unnamed protein product
基因别名: CALR; CALR1; Calregulin; cC1qR; CRT; CRTC; HEL-S-99n; RO; SSA
UniProt ID: (Human) P27797, (Mouse) P14211, (Rat) P18418
Entrez Gene ID: (Human) 811, (Mouse) 12317, (Rat) 64202